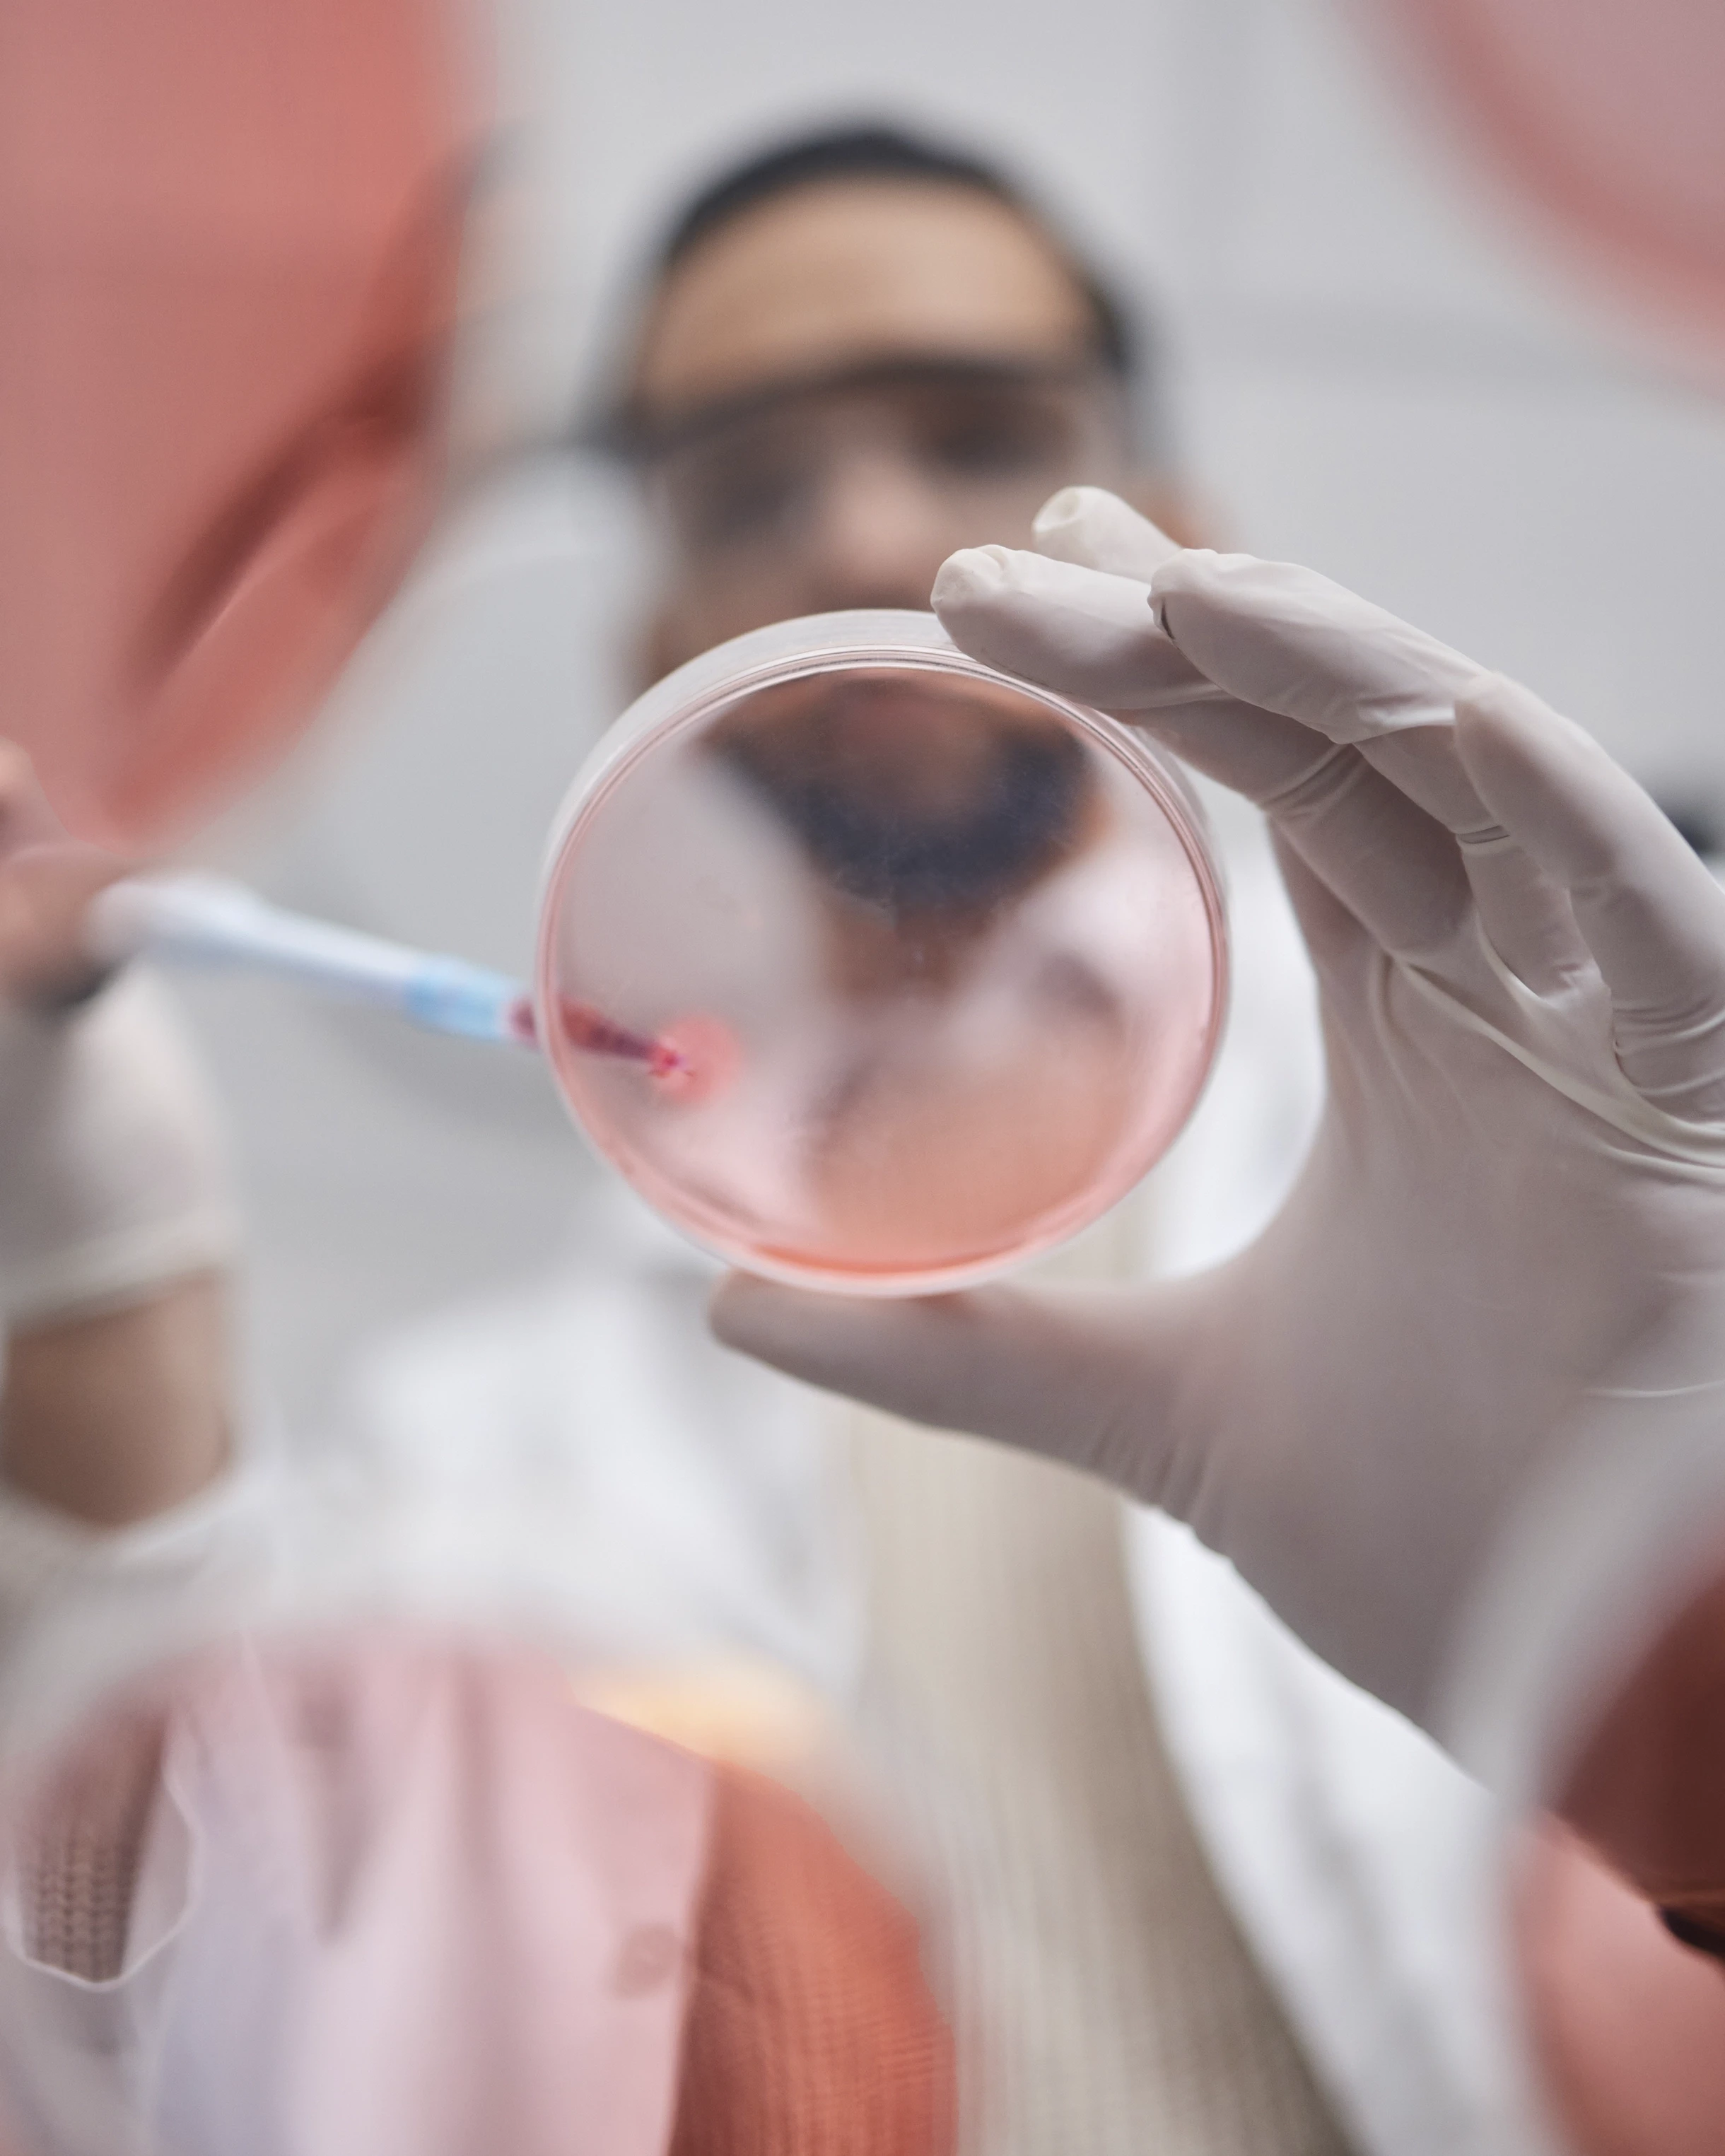

Think. Create. Change.
Nuuma,
Innovating in genomics, improving lives
Between scientific rigor and human connection, between technology and humanity
Genetics has revolutionized medicine. It tells us where we come from, how we function, and increasingly, where we might be headed. But while technology has begun to decode this complex system, its language remains inaccessible to most, disconnected from the very people it’s meant to transform. That’s how Nuuma was born, to take genetics into the future, not only through science, but through human experience. But to fulfill that promise, the brand needed more than a name: it needed an identity capable of turning genetic innovation into something understandable, relatable, and applicable. We accompanied them on this journey to give soul to a concept that still felt like it belonged to the future, and to shape it into a brand with purpose, strength, and vision.
More info
Nuuma,
Innovating in genomics, improving lives
Between scientific rigor and human connection, between technology and humanity
Genetics has revolutionized medicine. It tells us where we come from, how we function, and increasingly, where we might be headed. But while technology has begun to decode this complex system, its language remains inaccessible to most, disconnected from the very people it’s meant to transform. That’s how Nuuma was born, to take genetics into the future, not only through science, but through human experience. But to fulfill that promise, the brand needed more than a name: it needed an identity capable of turning genetic innovation into something understandable, relatable, and applicable. We accompanied them on this journey to give soul to a concept that still felt like it belonged to the future, and to shape it into a brand with purpose, strength, and vision.
More info
Nuuma,
Innovating in genomics, improving lives
Between scientific rigor and human connection, between technology and humanity
Genetics has revolutionized medicine. It tells us where we come from, how we function, and increasingly, where we might be headed. But while technology has begun to decode this complex system, its language remains inaccessible to most, disconnected from the very people it’s meant to transform. That’s how Nuuma was born, to take genetics into the future, not only through science, but through human experience. But to fulfill that promise, the brand needed more than a name: it needed an identity capable of turning genetic innovation into something understandable, relatable, and applicable. We accompanied them on this journey to give soul to a concept that still felt like it belonged to the future, and to shape it into a brand with purpose, strength, and vision.
More info






A visual and verbal identity that translates advanced science into something emotional and human.
A visual and verbal identity that translates advanced science into something emotional and human.
A visual and verbal identity that translates advanced science into something emotional and human.
A visual and verbal identity that translates advanced science into something emotional and human.


Over 20 years revolutionizing genetics, and the way we understand it

Over 20 years revolutionizing genetics, and the way we understand it

Over 20 years revolutionizing genetics, and the way we understand it

Over 20 years revolutionizing genetics, and the way we understand it

Helping brands
define their future, and that of the world around them.
New business
hello@wearesmall.es
Join the team
hello@wearesmall.es
Address
Alicante
Pl. del Alcalde Agatángelo Soler, 5, Oficina 3-5, 03015
T. +34 965 061 098
Madrid
C/Concepción Jerónima,
22 28012 Madrid
SmallCreative Band, S.L. © 2025
Helping brands
define their future, and that of the world around them.
New business
hello@wearesmall.es
Join the team
hello@wearesmall.es
Address
Alicante
Pl. del Alcalde Agatángelo Soler, 5, Oficina 3-5, 03015
T. +34 965 061 098
Madrid
C/Concepción Jerónima,
22 28012 Madrid
SmallCreative Band, S.L. © 2025
Helping brands
define their future, and that of the world around them.
New business
hello@wearesmall.es
Join the team
hello@wearesmall.es
Address
Alicante
Pl. del Alcalde Agatángelo Soler, 5, Oficina 3-5, 03015
T. +34 965 061 098
Madrid
C/Concepción Jerónima,
22 28012 Madrid
SmallCreative Band, S.L. © 2025